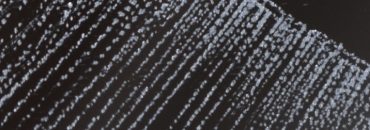
przykład graweru klasycznego

Lustra, które nadają wnętrzom charakter
To tutaj powstają ręcznie grawerowane lustra o unikatowym charakterze.
Każdy obiekt tworzony jest ręcznie, z dużą dbałością o detal, symbolikę i emocje.
Łączymy sztukę użytkową, rzemiosło oraz narrację wizualną, tworząc przedmioty,
które nie są wyłącznie dekoracją, ale również nośnikiem historii i znaczeń.
AKTUALNA OFERTa
Różne rodzaje graweru
Nowe & upcyklingowe
Znajdź swój styl
Lustra, które nadają wnętrzom charakter
Każde lustro jest inne
Nie produkujemy setek identycznych egzemplarzy. Każdy grawer to osobna historia i osobny proces twórczy.
Ręczna praca, nie automaty
Wzory są grawerowane ręcznie, z dbałością o detal i klimat. To sztuka użytkowa, nie taśma produkcyjna.
Nowe i upcyklingowe
Tworzymy zarówno nowe lustra, jak i te z odzysku — dając drugie życie przedmiotom z przeszłości.
Możliwość personalizacji
Chcesz zmienić motyw, dodać symbol lub tekst? Wiele luster można dopasować do Ciebie.
Szybka i darmowa wysyłka paczkomatem
Bez ukrytych kosztów i zbędnych komplikacji.